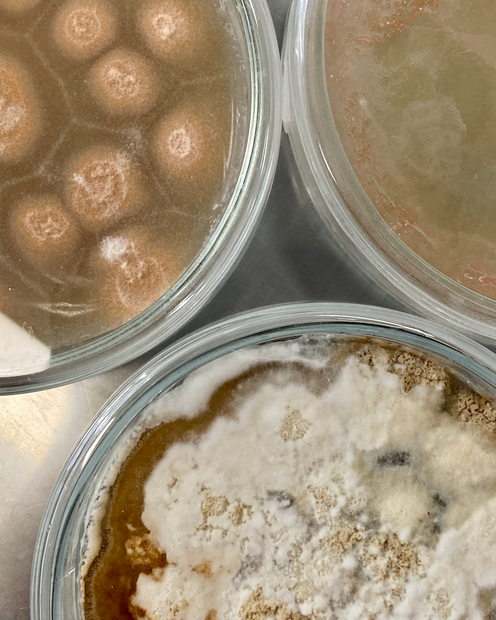

Foto: Julia Ihls

Foto: Julia Ihls


Foto: Julia Ihls
Titel: MYCOSKENE – Oder zur wuchernden Verflechtung einer singularisierten Zeit
MYCOSKENE ist eine material-theoretische Verflechtung rund um das Thema Mycelium, dem unterirdischen Hyphengeflecht der Pilze. Ob als sozio-philosophische Metapher, Bau- und Gestaltungsmaterial oder in Form einer multi-medialen Rauminstallation – in ihrer Arbeit folgte die Szenografin und Konzepterin Julia Ihls über 8 Monate den fein verwobenen Strukturen jener Organismen, die durch ihre eigene Zeitlichkeit und Qualitäten zu maßgeblichen Co-Gestaltenden wurden.
Diplom in Ausstellungsdesign und Szenographie 2021
Julia Ihls ist eine interdisziplinäre Forscherin und Gestalterin an den Schnittstellen von (Natur-)Philosophie, Medientheorie und Rauminszenierung. Nach ihrem Kunst- und Medienwissenschaftsstudium (M.A.) in Konstanz und Cork, sowie ihrem Szenografie-/Medienkunst Studium (Dipl.) in Karlsruhe arbeitete sie als Texterin, unter anderem für das ZKM Karlsruhe. Seit April 2021 leitet sie das Bio Design Lab der HfG Karlsruhe, wo sie – neben Lehre und Kuratierung – zu neuen (Bio-) Materialien und Konvivialismus forscht.